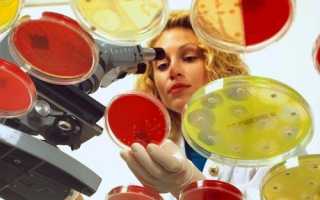

Посев различных бактерий представляет собой один из наиболее эффективных и широко распространенных способов, который в настоящее время активно применяется в сфере медицинской микробиологии. Также данный метод незаменим в области биотехнологии, где он играет важную роль в изучении различных свойств как биологического, так и биохимического характера. Под данным методом подразумевается процесс культивирования микроскопических организмов с использованием питательных сред, различающихся между собой по характеристикам и свойствам.
Бактериологические посевы могут проводиться с целью тщательного исследования отделяемых клеток глаз, половых органов человека, а также с целью максимально точного анализа крови, мочи или кала. Также выполняются бактериальные посевы спермы и мокроты для исследования. Довольно часто встречается процедура посева на анаэробные бактерии.
Какими бывают среды для питания бактерий
При выборе среды для осуществления посева в первую очередь следует ориентироваться на характер содержания, присущего бактериям, которые являются главным объектом исследования. В том случае, если необходимо получить изолированные колонии бактерий, а также определить чистую культуру, следует выполнять посев на плотные питательные среды.
Но если материал, подверженный исследованию, содержит в себе не очень большое количество микроорганизмов, можно в этих целях использовать жидкую питательную среду.
Существует несколько разновидностей питательных сред, в которых осуществляется бактериальный посев. Итак, принято различать простые и специальные среды, а также элективные и дифференциально-диагностические. Каждая категория сред питания отличается своими индивидуальными особенностями и характеристиками.
Простые питательные среды, в свою очередь, бывают как плотными, так и жидкими. В первом случае это мясопептонный агар, а во втором – мясопептонный бульон.
Главной особенностью специальных сред является абсолютная замена основы либо смешивание ее с другим компонентом, обладающим специфическими свойствами и характеристиками. В результате такого процесса можно выделить следующие виды питательных сред:
- агар на основе сыворотки;
- агар на основе казеина и активированного угля;
- яичная среда, открытая бактериологами Леванштейном и Йенсеном;
- бульон на основе агара и стерильной дефибринированной крови кролика, лошади или барана.
Известны в микробиологии и элективные питательные среды, отличительной чертой которых является получение роста только того из микроорганизмов, который на данный момент представляет интерес для исследования.
К элективным средам относят:
- пептонную воду;
- щелочной агар;
- среду Мюллера;
- среду Леффлера;
- желточно-солевой агар;
- селенитовую среду.
С целью исследования сальмонелл бактерии высеиваются на селенитовую среду и среду Мюллера. Наиболее эффективной для работы с коринебактериями дифтерии признана питательная среда Леффлера. Для стафилококка бактерии высеивать необходимо на желточно-солевой агар, а для холерного вибриона – в пептонную воду.
При помощи дифференциально-диагностических питательных сред появляется возможность проведения максимально точной идентификации отдельно взятых категорий, групп и типов бактерий. Среди данных сред можно выделить два основных типа – это:
- среда Сабуро, для которой характерно добавление антибиотика;
- среды Гисса, также известные под названием «пестрый ряд».
Врачи подчеркивают, что посев бактерий является важным этапом в диагностике инфекционных заболеваний. Основные принципы этого процесса включают выбор подходящей среды для роста микроорганизмов и соблюдение стерильности на всех этапах. Специалисты отмечают, что правильный сбор образцов и их транспортировка имеют критическое значение для получения достоверных результатов. Кроме того, важно учитывать время инкубации, так как разные бактерии требуют различных условий для роста. Врачи также акцентируют внимание на необходимости интерпретации результатов с учетом клинической картины пациента, что позволяет более точно определить источник инфекции и назначить адекватное лечение.

Какие различают способы и техники посева
Принято различать несколько техник и методов посева. В большинстве случае данный процесс осуществляется при помощи специальных микробиологических петель. При посеве на специальные чашки Петри данный процесс происходит с применением особых игл или шпателей, изготовленных из стекла или металла. Такой инструмент, как бактериальная петля, можно с уверенностью назвать универсальным, поскольку он применяется в разных техниках бактериального посева. В случае с жидкими материалами применяют специальную петлю в сочетании с пипетками – пастеровскими или градуированными.
Инструмент под названием чашка Петри предназначен специально для осуществления посева на плотные питательные среды. Это выполненный в форме невысокого и плоского цилиндра лабораторный сосуд, изобретенный в 1877 году знаменитым немецким бактериологом Юлиусом Ризардом Петри, который являлся ассистентом микробиолога Роберта Коха. Для изготовления чашки Петри, как правило, используют стекло либо полистирол с прозрачной текстурой. Самый широко используемый размер чашки Петри – высота до 15 миллиметров и диаметр от 50 до 100 миллиметров.
В данном случае техника бактериального посева такова: немного приоткрывают крышку чашки Петри, а затем наносят на поверхность плотной питательной среды – агара – требуемое количество посевного материала.
После того как произойдет инкубация бакпосева, бактерии начнут расти густо и равномерно, превращаясь в полноценную культуру и подразделяясь на отдельные колонии.
В данном процессе можно использоваться как стеклянные, так и пластмассовые чашки Петри. Первый вид предназначается для многоразового, а второй – для одноразового применения. Пластиковые чашки Петри являются стерильными, а поставляют их в специальных надежных герметических упаковках. Стеклянные сосуды, в свою очередь, требуют тщательной стерилизации перед осуществлением каждого нового посева.
Если при бакпосеве на плотные среды применяются чашки Петри, то в случае с жидкими средами можно использовать пробирки. Бактериальный посев позволяет быстро вырастить культуру бактерий с определенными свойствами и характеристиками.
Особенности бактериального посева мочи
Анализ, подразумевающий бактериальный посев мочи, предназначается для выявления, идентификации различных микроорганизмов, а также позволяет определить точную их концентрацию. Чтобы провести данную процедуру, мочу, которая является в данном случае основным биоматериалом, помещают в специальную среду питания, которая окажется для нее максимально благоприятной. Если после этого микроорганизмы не начнут расти, результат анализа является отрицательным.
Если же после проведения такого анализа концентрация микроорганизмов в моче окажется достаточно высокой для их размножения, то его результат, бесспорно, положителен.
Посев бактерий — это ключевой этап в микробиологии, который требует внимательного подхода и соблюдения определенных принципов. Многие специалисты подчеркивают важность стерильности на всех этапах работы, начиная от подготовки среды и заканчивая инкубацией. Это позволяет избежать контаминации и получить достоверные результаты. Также акцентируется внимание на правильном выборе питательной среды, которая должна соответствовать требованиям исследуемого микроорганизма.
Некоторые исследователи отмечают, что использование различных методов посева, таких как посев на чашках Петри или в жидких средах, может существенно повлиять на рост и развитие бактерий. Важно учитывать и условия инкубации: температура, влажность и время могут варьироваться в зависимости от типа бактерий. Кроме того, многие эксперты советуют вести тщательный учет всех этапов эксперимента, чтобы в дальнейшем можно было воспроизвести результаты. В целом, соблюдение этих принципов позволяет не только получить качественные культуры, но и углубить понимание микробиологических процессов.

В каких случаях пациентам назначают анализ мочи с посевом бактерий?
Проведение анализа с бактериальным посевом мочи является актуальным в нескольких случаях:
- при наличии инфекционных заболеваний органов мочевыводящей системы;
- при заболевании сахарным диабетом;
- при беременности;
- с целью уточнения диагноза, если заболевание носит нетипичный характер.
Для проведения этого вида анализа требуется утренняя порция мочи пациента, приблизительное количество которой составляет от трех до пяти миллилитров. Перед сбором мочи на анализ пациент должен обязательно провести соответствующие гигиенические процедуры, однако применять при этом средства с антисептическими свойствами нельзя. Доставку собранной мочи для анализа необходимо производить в кратчайшие сроки. С этой целью применяется стерильный одноразовый контейнер, который гарантирует правильную транспортировку и максимально точные результаты.
Вопрос-ответ

Какие условия требуются для прорастания бактерий?
Активная кислотность среды (рН) имеет решающее значение для роста многих микроорганизмов. Большинство бактерий лучше всего растет при рН, близком к 7, напротив, микроскопические грибы предпочитают слабокислые среды. Поэтому в приготовленных средах всегда следует определить значение рН.
Как сделать посев бактерий?
Исследуемый материал или культуру микробов засевают в пробирки с жидкой средой или в чашки Петри с плотной питательной средой. Посевы помещают в анаэростат, затем присоединяют его к насосу и выкачивают воздух. Степень разреженности воздуха определяют по показаниям вакуумметра.
Каковы пять идеальных условий для размножения бактерий?
FATTOM — это аббревиатура, используемая для описания условий, необходимых для роста бактерий: пища, кислотность, время, температура, кислород и влажность. Пищевые продукты обеспечивают идеальную среду для роста бактерий, поскольку содержат питательные вещества, энергию и другие компоненты, необходимые бактериям.
Каков метод посева по Голду?
Метод Голда (метод секторных посевов): материал помещают в сектор А чашки Петри, где осторожно распределяют, сделав несколько движений петлей по поверхности агара. Петлю стерилизуют обжиганием и проводят ею 4 раза по поверхности агара через сектор А в сектор 1.
Советы
СОВЕТ №1
Перед посевом бактерий убедитесь, что все используемые инструменты и материалы стерильны. Это поможет избежать контаминации и обеспечит чистоту ваших культур.
СОВЕТ №2
Выбирайте подходящую среду для роста бактерий в зависимости от их типа. Разные бактерии требуют различных питательных веществ и условий для оптимального роста.
СОВЕТ №3
Следите за температурными условиями и уровнем pH среды. Многие бактерии имеют узкий диапазон оптимальных условий, и их отклонение может негативно сказаться на росте и жизнеспособности культур.
СОВЕТ №4
Регулярно проводите мониторинг и документируйте изменения в росте и развитии бактерий. Это поможет вам лучше понять их поведение и оптимизировать условия для будущих посевов.